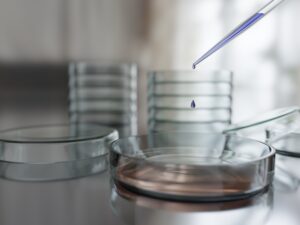

Columnコラム
植物のパワーが美肌を作る

【美容&健康コラム】 2024.03.25 Vol,156
MI美容顧問:川戸清弥

日々の生活において、私たちは「植物」から大きな恩恵を受けています。まだまだ植物が持つパワーについては解明されていない事も多いですが、今回のコラムは、健やかで美しい肌に導いてくれる化粧品に用いられる「植物エキス」のお話をしたいと思います。
植物は本来、その存在と繁殖の為さまざまな環境に適応する能力を持ち備えています。その植物の力を拝借しているのが人間なのです。その歴史は古く、薬・癒し・衛生・保存・害虫駆除等々私たちの生活には今も欠かせない物となっています。勿論美容の分野においても多くの植物が用いられて来ました。現在では化粧品・浴用剤・アロマオイル・整髪料・育毛剤や歯磨き粉・香水に至るまで数えきれない程のアイテムに植物エキスは使用されています。
最近ではオーガニックコスメも人気ですね。肌に優しいイメージの植物ですが作用は様々で、肌にとって有効な作用ばかりではありません。植物の部位によっても作用は違い、葉・茎・花びら・根・樹皮・種・果実等々採取される部位によって作用は大きく変わって来ます。そして同じ植物であっても産地や収穫時期によって効果は微妙に変わり、抽出方法においても違いが出るようです。そして漢方薬などと同様に一番作用に違いが出るのは、抽出エキスをどの様にブレンドするかで応用も多様化します。植物には数えきれない可能性があるのです。

「ファイトケミカル」という言葉を聞いたことがありますか?ファイトケミカルとは、ギリシャ語で「ファイト」=「植物」・「ケミカル」=「科学物質」を意味します。植物が寒暖差や紫外線・昆虫などから身を守るために作り出した色素や香り・辛み・ヌメリ等の成分の事で数千種類存在すると言われています。決して必須栄養素という訳ではありませんが、様々な病気を予防する効果が期待されており私たちの身体にとって、とても重要な働きをしてくれることがわかってきています。勿論毎日の食事において摂取する事が望ましいとされていますが、肌に塗る事での有効性も抗老化作用やシミ予防・毛穴の引き締め・殺菌作用・抗炎症作用等々多くの効果が期待されています。

例えばコアラが大好きなユーカリの葉には、水分・脂質・糖分・タンニン・タンパク質・カルシウムがバランスよく含まれており、コアラにとっては完全栄養食と言われています。特にユーカリの葉にはファイトケミカルの種類の中の「タンニン」(*ポリフェノールの一種)が含まれている事で、強い抗酸化作用で肌の老化を防ぎ、開いた毛穴の収斂作用にも優れているのです。ユーカリの葉を私たち人間は食べるわけにはいきませんが、ユーカリの葉から抽出したファイトケミカルの中の成分を毎日のスキンケアに役立たせる事は出来ます。これからも植物が作り出す素晴らしくパワーのある成分を、美しく健康な肌つくりに役立てて行きましょう。近い将来、植物がもつ不思議な力で老いる事への不安が解消される日がやって来るかもしれませんよ。